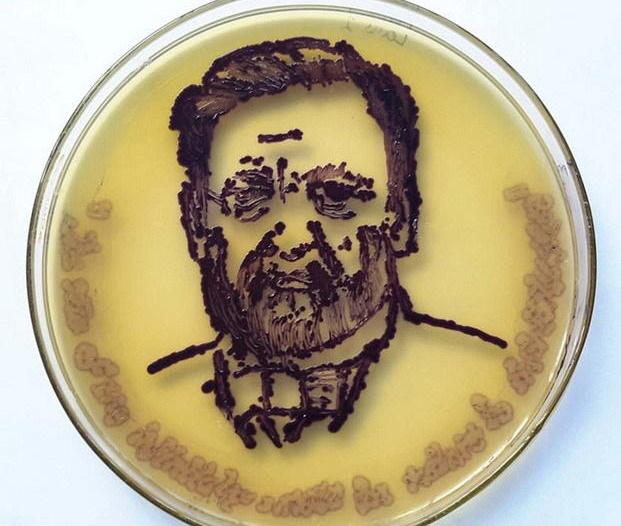
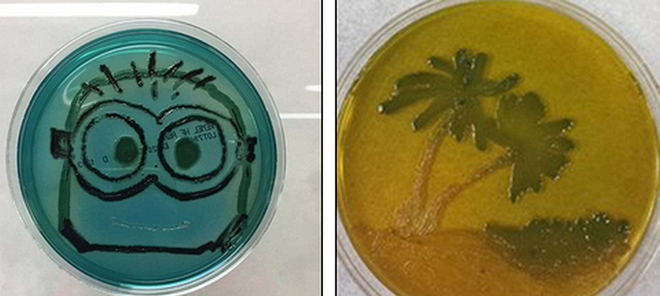

艺术家使用粪便细菌等微生物“培育作画”

琼脂艺术挑战赛是美国微生物学会(ASM)承办的一次新颖独特竞赛,甚至使用人体皮肤和粪便中的细菌“培育作画”。如图所示,这是获奖作品第一名“神经细胞”,使用涅斯捷连科氏菌(黄色部分)、异常球菌(橙色部分)和鞘氨醇单胞菌(红色部分)绘制的。

这是此次大赛第二名——“纽约生物群落地图”,这些盘子以纽约街道地图为模板,一些细菌在模板中生长。

阿根廷冰泉港实验室一位博士后研究生获得了此次大赛第三名,他的作品叫做“收获季节(左图)”,是培育酵母菌形成的;右图作品叫做“细胞至细胞”。

如图所示,这是研究人员使用粘质沙雷氏菌和不同大肠杆菌在半乳糖苷溶液中培育形成红色、白色和蓝色国旗。

左图作品叫做“这是粪便吗?”图中黑色轮廓是使用沙门氏菌制造的硫化氢形成的猫头鹰面孔;右图作品叫做“双歧杆菌的微型花朵”,是使用双歧杆菌亚种形成的,这种益生菌广泛使用于乳制品。

图中作品叫做“肠道细菌花园”,是使用多种肠道细菌“混合绘制”,其中包括:大肠杆菌(淡紫色)、柠檬酸杆菌(蓝绿色)、佛里德兰德氏杆菌(深蓝色),这些肠道细菌养殖在发色体琼脂中,琼脂会随着不同细菌而改变颜色。

左图肖像是使用紫色杆菌设计的,紫色杆菌是由微小、染色微粒青紫色杆菌素生成的,形成许多对比颜色,可清晰地看到人物肖像的头发和眼镜,同时,黄色菌株作为肖像背景底色;右图是盛开的太阳花和黑色蝴蝶,黑色蝴蝶是由沙门氏菌生长形成,太阳花是由大肠杆菌生长形成。
图中是法国著名微生物学家路易-巴斯德的肖像,艺术家在琼脂上培养青紫色素杆菌,通常青紫色素杆菌会导致动物和人体感染,它们是一种“条件致病菌”。青紫色素杆菌有能力生长在任何媒介,并制造一种叫做“青紫色素杆菌素”的抗氧化剂。
左图作品叫做“微小下属”,是动画片《卑鄙的我》中的小黄人角色图案,这是弧菌在琼脂中培养生长形成的;右图作品叫做“沙滩”,也是弧菌培养形成的,弧菌种属存在于甲壳纲动物,如果人体摄入将损害身体。

发表你的评论吧返回顶部
!评论内容需包含中文
